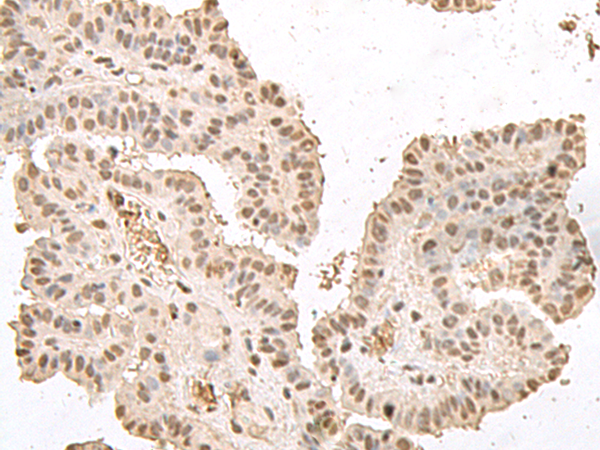

-
分类: 科研抗体货号: P09791别名: NOD5; NOD9; NOD26; DLNB26; CLR11.3应用: IHC反应种属: Human
-
分类: 科研抗体货号: P09762别名: GLYA; SHMT; HEL-S-51e应用: WB,IHC反应种属: Human
-
分类: 科研抗体货号: P09777别名: QARS; GLNRS; MSCCA; PRO2195应用: IHC反应种属: Human
-
分类: 科研抗体货号: P09790别名: TOP; MP78; EP24.15; MEPD_HUMAN应用: WB,IHC反应种属: Human, Mouse, Rat
-
分类: 科研抗体货号: P09776别名: AIP1; NORI-1; HEL-S-52应用: WB,IHC反应种属: Human, Mouse, Rat
-
分类: 科研抗体货号: P09789别名: PPM2; TYW4应用: IHC反应种属: Human, Mouse, Rat
-
分类: 科研抗体货号: P09806别名: HMG17应用: IHC反应种属: Human, Mouse, Rat
-
分类: 科研抗体货号: P09788别名:应用: IHC反应种属: Human, Mouse
-
分类: 科研抗体货号: P09786别名: Hulp1; NULP1; FKSG26; PRO2620; hKIAA1049应用: WB,IHC反应种属: Human, Mouse
-
分类: 科研抗体货号: P09805别名: EPM2; MELF应用: IHC反应种属: Human, Mouse, Rat

鄂公网安备42018502007531号
鄂公网安备42018502007531号

